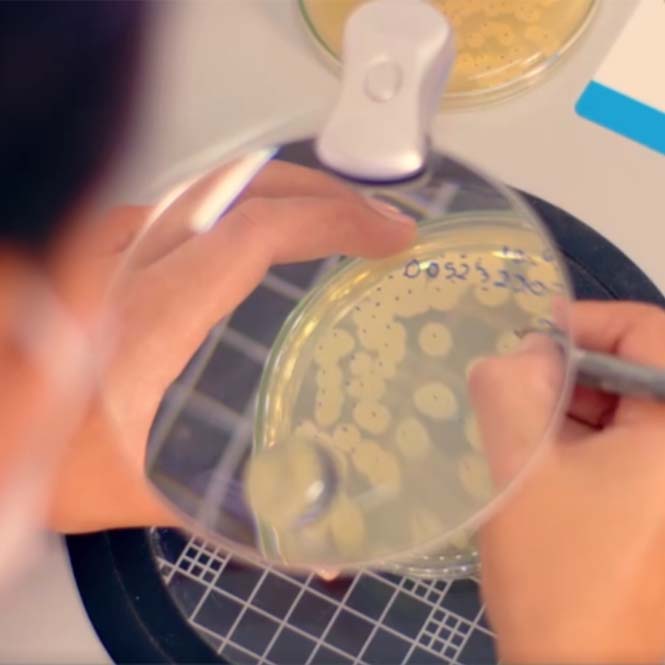

você otimiza resultados e garante
uma safra mais produtiva


Biosphera
Onde a tecnologia encontra a natureza para impulsionar o crescimento e o equilíbrio perfeito da sua lavoura.
Confira Nossas Linhas

Construir a agricultura do futuro com biossoluções inovadoras!
Somos uma indústria de insumos biológicos que se destaca no Brasil por seu compromisso com inovação e sustentabilidade.
- Paixão - pelo que fazemos e por quem fazemos.
- Inovação - através de pesquisas e avaliações constantes.
- Qualidade – excelência desde os nossos produtos até o atendimento.
- Sustentabilidade – suprir as necessidades da geração atual, sem esgotar os recursos futuros.





Our scale and reach to client Satisfaction
Com foco em sustentabilidade
Temos o compromisso com os princípios ESG em todas nossas estratégias.
Impulsionamos a produtividade no campo com tecnologias seguras, proporcionando colheitas prósperas hoje e que preservam o amanhã.
a qualidade é nossa assinatura.
Nossos produtos são submetidos a rigorosos processos industriais que asseguram a excelência do produto final. A combinação de equipamentos de última geração, uma equipe altamente qualificada e controles precisos são os pilares que sustentam a nossa busca incessante pela perfeição.
Equipamentos de última geração
Equipe altamente qualificada
Rigorosos controles nos processos produtivos

Na busca incessante por avanços, nossas tecnologias são frutos de intensas pesquisas e inovações, com o intuito de elevar a agricultura a novos patamares.
Nosso compromisso é impulsionar o seu sucesso agrícola, oferecendo soluções biológicas que transcendem os limites tradicionais da agricultura. Com uma visão centrada na sustentabilidade, nossa empresa tem o prazer de apresentar nosso diversificado portfólio, meticulosamente elaborado para atender às diversas necessidades dos agricultores modernos.
RIZOSPHERA TROPICI
- Produção de fitormônios para maior e melhor desenvolvimento vegetal
- Maior desenvolvimento radicular
- Protetor bacteriano com biopolímeros, osmoprotetores e complexo de açúcares
- Segurança, proteção e compatibilidade dos microrganismos no tratamento de sementes
NODGROW SOJA +
- Produção de fitormônios para maior e melhor desenvolvimento vegetal
- Maior desenvolvimento radicular
- Protetor bacteriano com biopolímeros, osmoprotetores e complexo de açúcares
- Segurança, proteção e compatibilidade dos microrganismos no tratamento de sementes
NODGROW LÍQUIDO
- Produção de fitormônios para maior e melhor desenvolvimento vegetal
- Maior desenvolvimento radicular
- Protetor bacteriano com biopolímeros, osmoprotetores e complexo de açúcares
- Segurança, proteção e compatibilidade dos microrganismos no tratamento de sementes
NITROSPHERA ELKANII TURFA
- Turfa de fácil aplicação e pH idea
- Umidade adequada
- Menor custo de produção
- Fonte de nitrogênio biológico de baixo custo
NITROSPHERA FUSION
- Maior volume de calda para aplicação no sulco
- Bactérias selecionadas e testadas
- Fonte de nitrogênio biológico de baixo custo
- Alta concentração de pureza
NODGROW SOJA T
- Aporta alta carga bacteriana por semente, com baixo volume de calda
- Alta concentração = maior quantidade de bactérias por semente
- Dispensa adubação nitrogenada
- Possui aditivos que aumentam a sobrevivência das células em situação de estresse
Temos uma equipe preparada para lhe atender
Orçamentos
Seja um distribuidor Biosphera
nossa equipe comercial ficará feliz em elaborar uma proposta que se alinhe perfeitamente aos requisitos da sua operação.
Notícias Biosphera
Compartilhamos conteúdos informativos, dicas práticas, histórias inspiradoras para impulsionar o seu sucesso no campo. Junte-se a nós na jornada rumo a uma agricultura mais eficiente, sustentável e produtiva. Cultive conhecimento com a Biosphera!


















